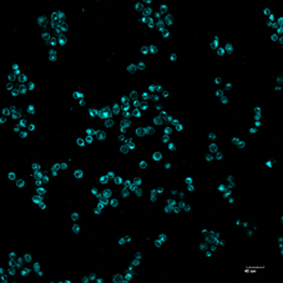

博士
with certificate of graduation for doctorate study
e-mail:13d631943517ffaa8801b917db45072536755483c74bddeaec0f5112ca5e8aed400fd2ef49438c280f719b7058291ef9254d0ca59140e06ed591c6ff32c291dc782113c1cf7d406715a658c563dd37cfe4b392b2d2f81a6c6157608ce3e666d988b60ac04afb1caf473a07c50482d0df1eadd30e3137b2641edf889339d0d5f1
view morepostaladdress : 17d304e94242d42751e13297d4da8ca90858bd3ee6ea187cecf036ffdd6513d002ca2e87cf88a9c52c4b88758c3d55ece462e17e500a9d489b363d642a72aae4240bdf5565317b7df8d5ddf43d750e886a1187e40bf7e4e94565104ce2a36c44b03a7a82e4afb147771a20b9830856555805b3eb3926a0d941c86cebcb607145
email : 13d631943517ffaa8801b917db45072536755483c74bddeaec0f5112ca5e8aed400fd2ef49438c280f719b7058291ef9254d0ca59140e06ed591c6ff32c291dc782113c1cf7d406715a658c563dd37cfe4b392b2d2f81a6c6157608ce3e666d988b60ac04afb1caf473a07c50482d0df1eadd30e3137b2641edf889339d0d5f1

一、有机光电材料的设计与合成

二、光谱分析检测及生物成像
联众游戏 copyright guilin university of technology.
"this information is provided by me, and the author is responsible for it."
click: | the last update time:..